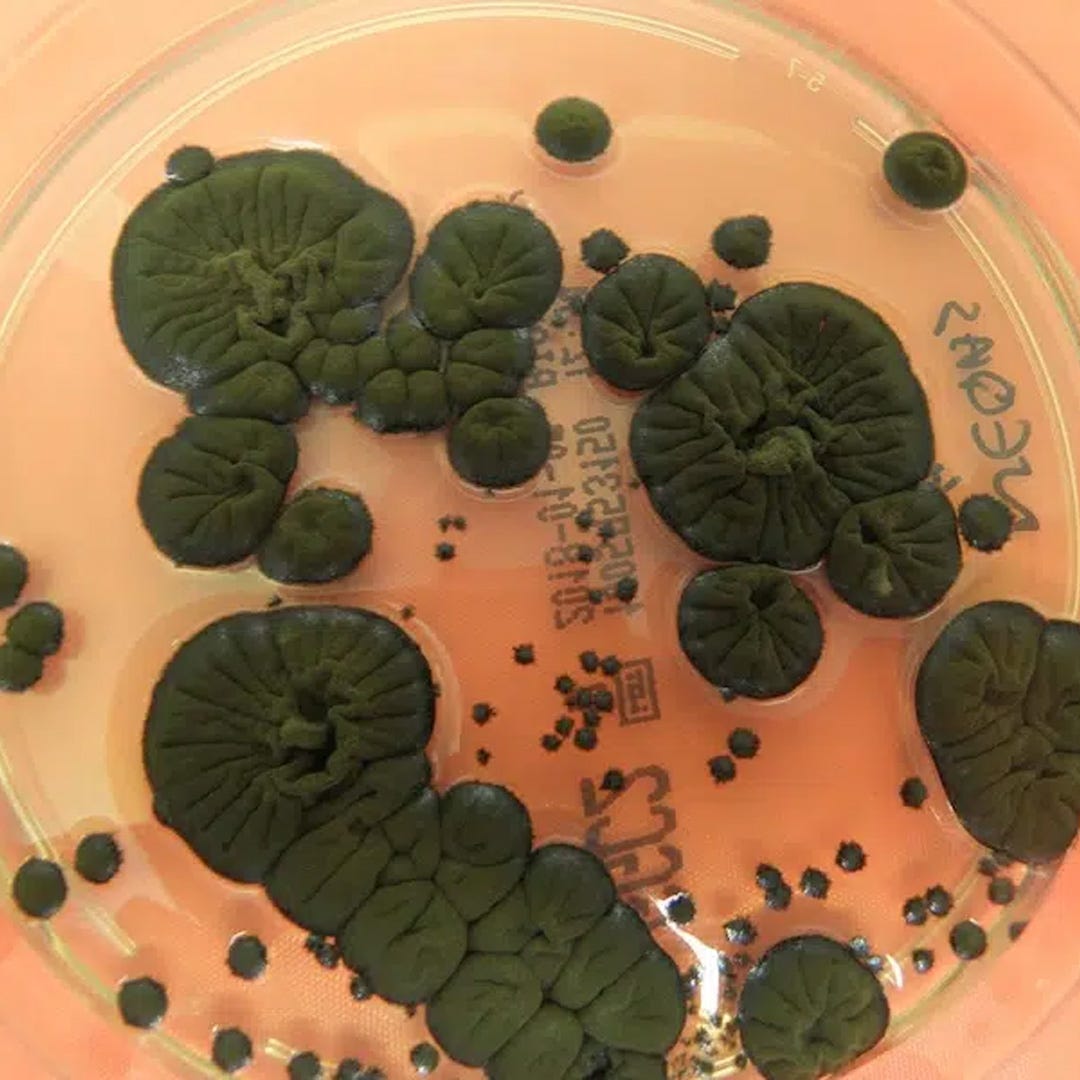

Design Digest #1
Inventive Spirits
I’m delighted to bring you the first instalment of Design Digest, an occasional series of despatches from the front lines of the design universe.
For most people January is a time to lie low and recover from their Christmas excesses, but not for intrepid gadget-hunters who flock to the Consumer Electronics Show in Las Vegas. This year, the headlines were hogged by domestic robots. LG launched LG CLOiD, a prototype humanoid designed to handle housekeeping chores like unloading the dishwasher or toasting your croissants in the oven. The vision is alluring: freed from the shackles of domestic drudgery, we will have plenty of time for leisure activities such as playing with robot toys like the OlloNi (odd capitalisations are clearly de rigueur for robot names).
Looking a bit like the eponymous alien in ET, OlloNi is a robotic pet designed to react to your emotions by displaying different graphics on its screen of a face. If you fancy something more discreet there is Sweekar, developed by Chinese startup Takway.
Envisioned as an upgraded version of the Tamagotchi, the Sweekar will respond to your conversations and other interactions and “grow” from a baby to an adult, as well as emitting “body warmth” and “gentle breathing rhythms”. It can also be dressed in different outfits and looks rather cute dangling from your bag. Could this be the next Labubu?
For those who think all toys are going digital they are not far wrong - even Lego has announced the introduction of smart bricks. These are packed with sensors which enable them, for example, to make a woosh-woosh sound if a light sabre is waved about in the Star Wars set.




Other interesting recent inventions include a knife that cuts better by emitting high frequency vibrations, a roll-out bed inspired by the way mattresses are compressed before they are shipped and a Moka coffee pot with a weird spiral base designed to speed up your morning brew by improving heat circulation.
Elsewhere, architects are reeling from further interventions from President Trump, who fancies himself as the nation’s designer-in-chief. He is reportedly demanding the proposed new Washington Commanders NFL stadium to incorporate “classic” design features. Trump is also mulling the idea of adding an extra floor to the west colonnade of the White House in order to balance the gargantuan proposed new ballroom in the now-demolished east wing. Surely it would be easier to reduce the scale of the yet-to-be-built ballroom? But what do I know, I’m not a very aesthetic genius property developer.
On an upbeat note, scientists have discovered that a particular species of black fungus has been thriving inside the ruins of the Chernobyl nuclear reactor. The hypothesis is that the fungus is quietly eating the radioactive waste in a process known as radiosynthesis. None of this is proven yet and more research is required, but isn’t refreshing to hear some happy news which, for once, points to a brighter future?
For more bright and cheery design inspirations come visit us at www.do-shop.com.

Looking forward to a very long and exciting serie of Design Digest despatches ! 🥳👍🏻
Nice assortment of design items.